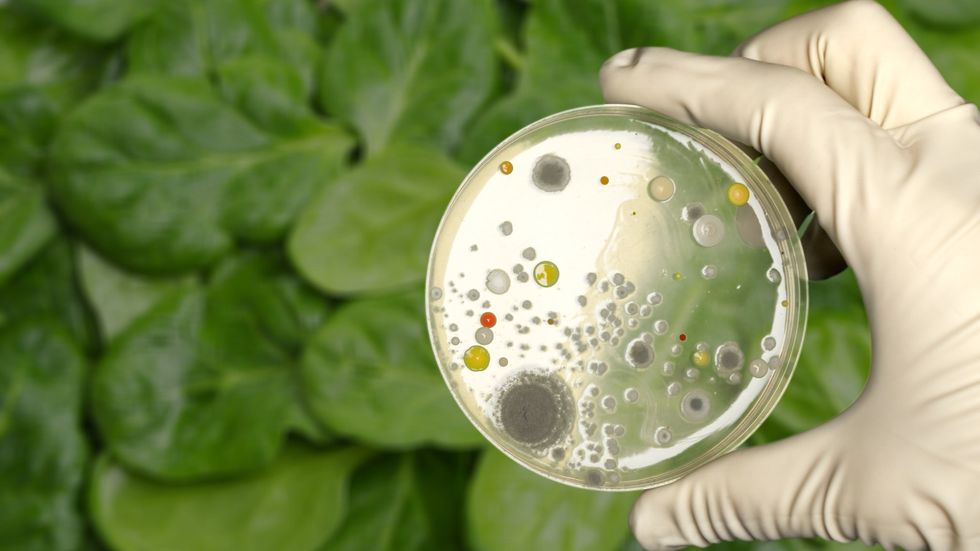

Duken të shëndetshme, por janë të rrezikshme: Perimet në qese mund t’ju sëmurin

Ndoshta blini ushqime të caktuara për të kursyer kohë kur përgatitni vakte. Perimet me gjethe jeshile të lara paraprakisht në qese, si marule ose spinaq, mund të duken si një zgjedhje e mirë nëse po përpiqeni të ushqeheni shëndetshëm. Megjithatë, nuk është tamam kështu...
Sipas ekspertëve të sigurisë ushqimore, perimet e lara paraprakisht në qese, në fakt, nuk janë opsioni më i sigurt. Bakteret dhe kontaminimi janë më të zakonshme nga sa mendoni kur bëhet fjalë për këtë lloj produkti.
"Edhe pse konsumatorët presin si komoditet ashtu edhe siguri, realiteti është se perimet e lara në qese vazhdojnë të përfaqësojnë një nga artikujt më të rrezikshëm në supermarkete, për shkak të potencialit për kontaminim përgjatë gjithë zinxhirit të furnizimit", thotë Darin Detwiler, profesor i politikave ushqimore në Universitetin Northeastern dhe autor i librit Siguria Ushqimore: E kaluara, e tashmja dhe e ardhmja.
Ai shmang blerjen e perimeve të tilla pikërisht për shkak të rrezikut të kontaminimit serioz me bakterien Escherichia coli.
"Kur shikoni shpërthimet e kaluara, sallatat e paketuara shpesh kanë qenë shkaku kryesor i sëmundjeve të shkaktuara nga ushqimi, disa prej tyre kanë çuar në shtrim në spital, dështim të veshkave (sindroma hemolitike uremike) dhe madje edhe vdekje", thotë Detwiler.
Shumë faktorë në zinxhirin e furnizimit mund të çojnë në kontaminimin e perimeve jeshile me patogjenë si E. coli, listeria ose salmonela, të cilat mund të shkaktojnë probleme serioze shëndetësore, shkruan HuffPost, përcjell Telegrafi.
"Zarzavatet me gjethe të paketuara lahen dhe përpunohen në sasi të mëdha, gjë që në fakt lejon që patogjenët të përhapen më shpejt", shton Olivia Roszkowski, shefe kuzhine dhe instruktore për aftësitë e kuzhinës me bazë bimore dhe sigurinë ushqimore në Institutin e Arsimit Kulinar në Nju Jork.
Shpërthimet e lidhura me perimet me gjethe ndodhin më shpesh nga sa mund të prisni, kështu që në vitin 2020, FDA nisi një plan veprimi për të zvogëluar llojet e ndryshme të E. coli në perimet me gjethe, dhe plani u përditësua në vitin 2023.
Për shembull, lloji Escherichia coli O157:H7, i cili prodhon toksinën shiga, shpesh shoqërohet me shpërthime të shkaktuara nga marule dhe është shumë i rrezikshëm sepse një sasi shumë e vogël është e mjaftueshme për të shkaktuar sëmundje serioze.
"Ky rrezik nuk është teorik, është konfirmuar vazhdimisht në praktikë", thotë Detwiler.
Ekziston mundësia që patogjenët të vijnë në kontakt me perimet edhe pasi ato mbërrijnë në fabrikat e përpunimit. Perimet që blini në një qese zakonisht vijnë nga disa ferma të ndryshme, gjë që e bën të vështirë gjurmimin e origjinës dhe rrit rrezikun e kontaminimit.
Perimet me gjethe përpunohen në fabrika të centralizuara dhe më pas shpërndahen, gjë që u përshtatet prodhuesve, por jo konsumatorëve nga pikëpamja e sigurisë ushqimore.
"Perimet nga ferma të ndryshme përzihen, lahen dhe paketohen së bashku, kështu që një gjethe e infektuar mund të kontaminojë mijëra qese në disa vende", shpjegon Detwiler.
Nëse po mendoni, "Epo mirë, do t’i laj perimet e mia të para-lara vetëm për të qenë më i sigurt", mendoni përsëri. Larja në shtëpi nuk i bën perimet më të sigurta sepse uji nuk mund t’i largojë të gjithë patogjenët, pohon Detwiler.
Përkundrazi, shpëlarja shtesë mund të sjellë baktere të reja që janë në sipërfaqen e punës ose lavaman.
"Perimet e para-lara nuk duhet të rilahen në shtëpi, pasi kjo mund të çojë në ndotje nëse lavamani, enët, pajisjet ose duart e personit që përgatit vaktin nuk pastrohen dhe dezinfektohen siç duhet."
E vetmja mënyrë për të hequr në mënyrë të besueshme patogjenët është trajtimi termik, nxehtësia i vret ato. Problemi me sallatën është se ajo konsumohet më shpesh e gjallë, gjë që e bën edhe më të vështirë uljen e rrezikut të sëmundjeve të transmetuara nga ushqimi, shton eksperti i sigurisë ushqimore.
Rekomandime nëse ende blini perime në qese
Kontrolloni datën e skadimit
Blini vetëm aq sa planifikoni të hani në një ose dy ditët e ardhshme.
Kushtojini vëmendje freskisë
Shmangni qeset që janë të lagështa, sepse një mjedis me lagështi favorizon zhvillimin e baktereve.
"Kontrolloni që marulja të duket e freskët, pa pjesë të zbehura ose të zbardhura, pasi kjo mund të tregojë ruajtje të dobët. Gjithashtu, shmangni qeset me gjethe të rrëshqitshme.
Shmangni luhatjet e temperaturës
Pas blerjeve, mos i lini perimet në një makinë, garazh ose banak të ngrohtë kuzhine. "Shmangni ndryshimet e papritura të temperaturës sepse ato shkaktojnë kondensim dhe krijojnë një mjedis të lagësht dhe të ngrohtë të favorshëm për rritjen e baktereve dhe prishjen më të shpejtë", thotë Roszkowski.
Ruajini perimet siç duhet
Perimet jeshile duhet të mbahen në frigorifer në një temperaturë prej 4°C ose më të ulët.
Blini koka marule në vend të perimeve të pastruara tashmë
Blerja e një koke të tërë maruleje ose një tufe spinaqi kërkon një hap shtesë larjeje dhe tharjeje, por në këtë mënyrë e zvogëloni ndjeshëm rrezikun e kontaminimit. "E gjithë koka ka më pak sipërfaqe për kontaminim të mundshëm krahasuar me zarzavatet me gjethe të prera paraprakisht dhe të përziera në qese", thotë Detwiler.
Ai këshillon larjen e tyre nën ujë të rrjedhshëm të ftohtë, pa i zhytur, për të hequr papastërtinë, mbeturinat dhe patogjenët e mundshëm. "Lani ato në shtëpi menjëherë para konsumimit." /Telegrafi/